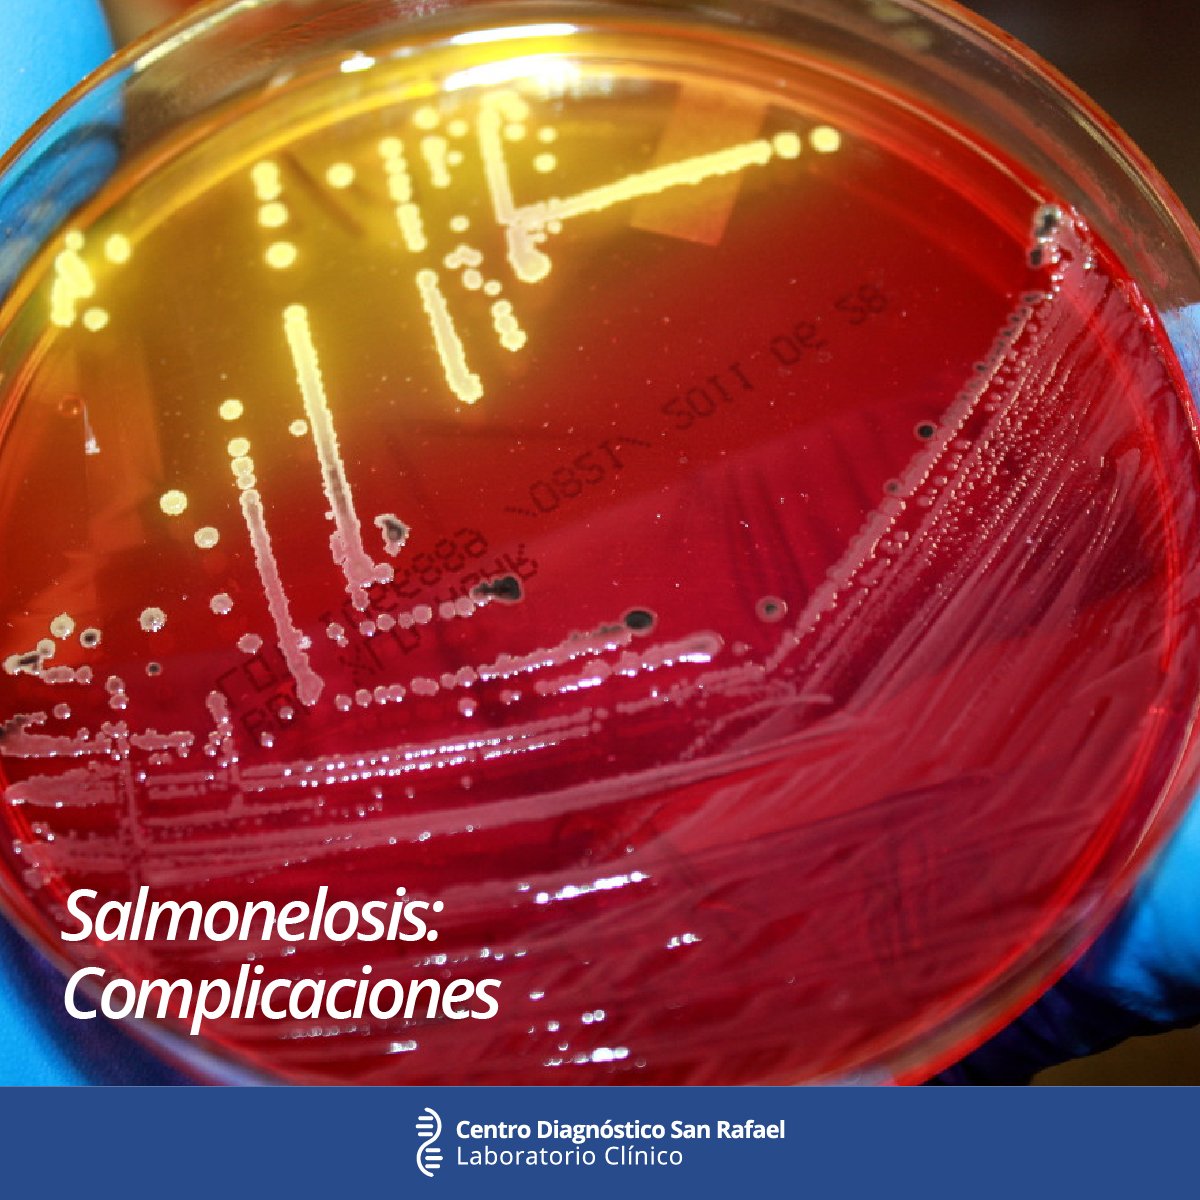

Лечение сальмонеллеза в домашних условиях: Симптомы и лечение сальмонеллеза у взрослых и детей, профилактика
Осторожно, сальмонеллёз!
Сальмонеллез – инфекционное заболевание, поражающее в первую очередь органы желудочно-кишечного тракта. Возбудителем сальмонеллеза являются бактерии рода сальмонелла. Для сальмонеллеза характерно тяжелое течение, а риск заражения болезнью достаточно велик, поэтому любой человек должен знать, как проявляется это заболевание, и как его избежать.
Сальмонеллез – что это такое?
Сальмонеллез относится преимущественно к зоонозным заболеванием. Так называются заболевания, передающимся к человеку от животных или от продуктов, получаемых от животных. Таким образом, источником заражения могут быть как живые животные (собаки, кошки, коровы, свиньи, дикие и домашние птицы, рыбы), так и продукты животноводства – мясо, молоко, яйца.
Бактерии рода сальмонелла относятся к категории грамотрицательных. Они отличаются большой устойчивостью к неблагоприятным воздействиям. Бактерии могут обитать в течение недель или месяцев в воде, на поверхностях предметов, в мясе и молоке животных при комнатной температуре.
Также они могут выдерживать значительное (до -80ºС) понижение температуры. Кипячение и нагрев до +100ºС быстро убивает микроорганизмы, однако в воде с температурой до +70ºС они могут жить в течение нескольких десятков минут.
Ни соление, ни консервация не убивает эти бактерии. Единственная их «ахиллесова пята» – воздействие дезинфицирующих средств – большинство из них быстро убивает бациллы сальмонеллеза. Также бактерии сальмонеллеза обладают значительной устойчивостью к большинству антибиотиков.
Механизм развития болезни
Инфицирование обычно происходит после контакта с зараженными животными, после приема пищи, содержащей сальмонеллы. Также не исключено инфицирование воздушно-капельным путем, через воду, предметы повседневного обихода. Источником заражения могут быть и другие люди, являющиеся носителями бацилл сальмонеллеза.
Далеко не каждый раз при попадании бактерий внутрь организма через рот происходит заболевание. Сначала бактерии попадают в желудок человека, содержащий желудочный сок.
Сальмонеллы чувствительны к кислой среде, поэтому желудочный сок, содержащий соляную кислоту, может убить некоторое количество бактерий. Поэтому наибольшей чувствительностью к бактериям обладают люди, имеющие проблемы с секрецией желудочного сока.
Если же желудочный барьер был благополучно пройден, то бактерии заселяют кишечник и начинают свою деструктивную деятельность. Они могут хорошо прикрепляться к слизистой оболочке кишечника и внедряться в поверхностные ткани. При этом бактерии могут выделять различные токсины, отравляющие организм и вызывающие недомогание, рвоту и диарею. Гибнущие сальмонеллы также выделяют опасные токсины.
Сальмонеллы также очень хорошо умеют обходить защитные силы организма. Обнаружив вторжение, иммунная система посылает навстречу возбудителям болезни специальные клетки – макрофаги. Однако сальмонеллы научились использовать эти клетки в свою пользу. Будучи поглощенными макрофагами, некоторые сальмонеллы не погибают, а перемещаются вместе с ними по кровотоку и таким образом переселяются в другие ткани организма.
Таким образом, сальмонеллы могут поражать не только кишечник, но и печень, почки, сердце и даже мозговые оболочки. Эта особенность возбудителей сальмонеллеза является причиной того, что болезнь может привести к тяжелым осложнениям и выйти далеко за пределы желудочно-кишечного тракта.
Сальмонеллезом может заболеть любой человек вне зависимости от возраста и пола. Тем не менее, наиболее подвержены ему маленькие дети и пожилые люди – из-за их ослабленного иммунитета. Кроме того, у них болезнь протекает в более тяжелой форме.
Болезнь имеет четко выраженную сезонную зависимость. В теплое время года наблюдается пик заболеваний. Однако заразиться сальмонеллезом можно в любой сезон.
Симптомы сальмонеллеза
Существует два основных варианта заболевания – гастроинтестинальный и генерализованный. Второй, в свою очередь, делится на тифозный и септический. Гастроинтестинальный вариант является наиболее легким, а септический – самым тяжелым, имеющим наибольшую вероятность летального исхода.
Гастроинтестинальная форма
Типичные симптомы при данной форме болезни:
- Высокая температура,
- Жидкий стул с характерными выделениями,
- Боли в области живота,
- Тошнота,
- Рвота.
Эта форма в целом не выходит за пределы желудочно-кишечного тракта. Инкубационный период болезни невелик. Обычно он составляет от 3 до 72 ч. После этого у больного поднимается температура, начинаются расстройства стула, тошнота и рвота.
Характерна острая боль в области живота, чаще всего в верхней части, в районе пупка. Симптомы сальмонеллеза также включают очень высокую температуру, которая может подниматься вплоть до + 40 ºС. Стул частый – до 10 раз за сутки и может приводить к обезвоживанию организма. Стул обычно имеет водянистую и пенистую консистенцию, содержит зеленые слизистые сгустки и обладает неприятным запахом. Кровянистые выделения могут появляться чуть позже, на третий день.
Кроме того, у больного может наблюдаться падение давления, тахикардия, изменение тонов сердца.
Эта форма обычно длится не более недели.
Гастритическая форма является разновидностью гастроинтестинальной формы. Обычно болезнь при ней протекает легче, диареи не наблюдается, лишь рвота, болезненные ощущения локализуются в области эпигастрия. Данная форма встречается довольно редко.
Тифозная форма
При тифозном сальмонеллезе симптомы поначалу напоминают симптомы гастроинтестинальной формы – рвота, диарея, высокая температура. Однако затем болезнь принимает черты, делающие ее схожей с сыпным тифом. На коже появляется сыпь, увеличиваются в размерах многие органы – селезенка, печень. Эта форма имеет более тяжелое течение и длится дольше – в некоторых случаях больше месяца.
Септическая форма
В большинстве случаев она характерна для лиц с ослабленным иммунитетом, пожилых людей, маленьких детей. У септической формы сальмонеллеза симптомы не ограничиваются лихорадкой и признаками общей интоксикации. Для нее также характерны инфекционные процессы в различных органах, прежде всего, в легких, почках, мочевом пузыре.
Могут наблюдаться поражения эндокарда и мозговых оболочек.
Для септического сальмонеллеза в большей степени характерны угрожающие жизни осложнения в виде отека легких и мозга, почечной и сердечной недостаточности. При этой форме сальмонеллеза лечение чрезвычайно осложнено.
Диагностика
Не всякие симптомы, включающие диарею и повышенную температуру, означают, что это сальмонеллез. Сальмонеллез, особенно на ранней стадии, не всегда бывает просто отделить от других инфекционных заболеваний желудочно-кишечного тракта, например, ротавирусной инфекции, дизентерии. Поэтому для определения возбудителя необходим анализ кала пациента. При генерализованных формах возбудителей можно выявить и в крови. Также важную роль в диагностике играет анализ действий, которые могли привести к заражению.
Как лечить сальмонеллез
Чем лечить болезнь, может решить лишь врач. В большинстве случаев сальмонеллеза лечение проводится в стационаре. В случае легких форм заболевания лечение может проводиться и в домашних условиях.
Однако это скорее исключение, поскольку сальмонеллез – коварная болезнь, и ее кажущееся легкое течение в любой момент может смениться обострением.
При легком сальмонеллезе лечение в основном симптоматическое. Если у человека гастроинтестинальный сальмонеллез, то основное внимание обращают на регидратацию организма, то есть восстановление им потерянной жидкости. Для этой цели используются водно-солевые растворы. Также в первые дни заболевания регулярно делаются промывания желудка и кишечника, применяются сорбенты, впитывающие бактерии и их токсины, проводят деинтокискационную терапию при помощи коллоидных растворов. Для восстановления функций пищеварения используются ферментные препараты (панкреатин, сухая желчь).
Кроме того, необходим прием препаратов – пробиотиков, восстанавливающих нормальную микрофлору кишечника.
Больному следует пить как можно больше жидкости. Голодная диета не показана, вместо нее следует использовать щадящую диету – вареные блюда, нежирные супы, каши.
Не рекомендуется принимать антидиарейные препараты, такие, как Лоперамид, так как они замедляют выведение токсинов из организма и могут привести к тяжелой интоксикации.
Антибиотики при сальмонеллезе легких форм используются редко. Это связано с тем, что сальмонеллы имеют высокую устойчивость к большинству антибактериальных препаратов и с тем, что антибиотики способны усугубить интоксикацию. Тем не менее, при тяжелом сальмонеллезе лечение может включать антибиотики. Также антибиотики применяются в тех случаях, когда иные формы терапии демонстрируют низкую эффективность. Чаще всего при терапии сальмонеллеза используются фторхинолоны, однако конкретный вид антибиотика может назначить только врач. Также существуют специальные препараты, содержащие вирусы-бактериофаги, активные против сальмонелл.
Вакцинации от сальмонеллеза не делается. Связано это с тем, что разновидностей бактерий, которые могут вызвать сальмонеллез, огромное множество – несколько сотен, и универсальной вакцины в данном случае разработать невозможно.
Кроме того, иммунитет к сальмонеллезу у человека обычно нестойкий и проходит примерно через год.
После выздоровления следует восстановительный период, который может занять несколько месяцев. Это поможет избежать негативных последствий сальмонеллеза.
Выздоровевшие пациенты, тем не менее, могут носить в организме сальмонеллы еще долгое время и могут быть опасны для окружающих из-за возможности их инфицировать. Также последствия сальмонеллеза включают дисбактериоз, который подлежит лечению пробиотическими препаратами.
Профилактика
Профилактика заболевания в принципе сходна с профилактикой других инфекций заболеваний желудочно-кишечного тракта, однако имеет и некоторые особенности. Они связаны с тем, что основной источник заражения – животные и плохо обработанные продукты, полученные от животных. Таким образом, для того, чтобы уберечься от заболевания сальмонеллезом, необходимо соблюдать простые правила – не есть сырые, плохо прожаренные или проваренные мясо, рыбу или яйца.
Следует помнить, что сальмонелла не погибает даже при длительной варке, в течение нескольких часов, в том случае, если толщина мяса составляет более 15 см. Таким образом, перед кулинарной обработкой мяса, птицы и рыбы, следует нарезать их как можно более мелкими ломтиками.
Особое внимание нужно обратить на яйца. Домашняя птица наиболее часто оказывается носительницей сальмонеллы. Поэтому следует отказаться от употребления в пищу сырых яиц и варить их как можно дольше – не менее 6 минут. Также необходимо обратить внимание на поверхность самих яиц, поскольку на них могут быть частицы птичьего помета. Следовательно, после того, как яйца брались руками, руки необходимо тщательно вымыть с мылом.
Правда, есть и исключение – перепелиные яйца крайне редко поражаются сальмонеллой, поэтому их можно есть даже сырыми. Однако их тоже обязательно следует мыть перед употреблением.
Также следует обратить внимание на процедуру разделки сырого мяса. Некоторые хозяйки могут использовать один и тот же нож и разделочную доску для разделки сырых мяса, птицы и рыбы и нарезки продуктов, употребляемых в сыром виде.
Так поступать не следует – для этих целей следует пользоваться различными приспособлениями. Мясные доски и ножи лучше всего мыть после использования. Также не следует употреблять сырое молоко – только кипяченое или пастеризованное.
Впрочем, сальмонеллы могут обитать и в продуктах, казалось бы, не имеющих отношения к животным, например, в кондитерских изделиях. Объясняется это тем, что для приготовления муки в подобных продуктах могли использоваться зараженные яйца. Поэтому вообще следует взять за правило не покупать сомнительных продуктов питания с рук, у уличных продавцов.
Остальные советы по профилактике сальмонеллеза совпадает со стандартными правилами гигиены – регулярно мыть руки, особенно после посещения улицы, контактов с животными, не пить некипяченую воду, и т.д. И, разумеется, укреплять иммунитет, лечить хронические заболевания, которые могут привести к уязвимости организма перед инфекцией.
Профилактика сальмонеллеза
Чем опасен сальмонеллез?
Сальмонеллез — острое кишечное заболевание (ОКИ), которое характеризуется резким повышением температуры до 38-39С, болями в животе, рвотой и жидким стулом.
Если вовремя не обратиться за медицинской помощью, результат этого заболевания может быть достаточно плачевный – рвота и жидкий стул приводят к обезвоживанию организма, из-за чего могут начаться проблемы с сердцем, а выделяющиеся токсины повреждают внутренние органы. Это особенно опасно для пожилых людей и маленьких детей. А ведь болеют сальмонеллезом в основном они.
Сальмонеллез – это заболевание, которое вызывается разными видами бактерий (Сальмонеллы разных групп), которые живут в разных условиях. Поэтому нельзя трепетно относиться к продуктам из яиц и при этом спокойно есть не просоленное сало с полной уверенностью, что сальмонеллезом явно не заразитесь. Это не так.
Фактором передачи у заболевших сальмонеллезом могут быть куриные яйца, приготовленные в домашних условиях блюда-это яичница и омлеты, варенные всмятку яйца, а так же сырые куриные яйца. Возможно, заболеть от не прожаренных кур-гриль, салатов домашнего приготовления и теста, замешанного на яйцах. Если курица-гриль недожаренная – лучше откажитесь от нее, выбросьте или на крайний случай доведите до готовности уже дома.
Поверьте, лечение обойдется гораздо дороже.
В единичных случаях факторами передачи было сырое козье молоко и свиное сало, молоко нужно кипятить, а сало – хорошо просаливать.
Несмотря на то, что куры и яйца – основной источник сальмонеллеза, выявить какого-то одного производителя (и, соответственно, принять меры) нельзя. Все продукты, послужившие источником заболевания, произведены разными производителями и в разных местах. Поэтому особую серьезность обретает фраза: «Ваше здоровье – только в Ваших руках».
Как же избежать сальмонеллеза?
Для этого достаточно соблюдать обычные правила гигиены и здравого смысла, которые с детства знакомы каждому. Эти правила относятся не только к сальмонеллезу, но и к остальным кишечным инфекциям и отравлениям в целом.
- После посещения туалета и перед едой нужно обязательно мыть руки с мылом.
- Нельзя есть полусырые продукты. Если Вы увидели, что мясо или курица недоваренные или недожаренные – не поленитесь, продолжите их приготовление.
Это гарантирует не только Вашу безопасность, но и вкусовые качества блюда. - Готовые продукты (особенно салаты, изделия с фаршем или с кремом) нужно хранить только в холодильнике. Иначе они могут просто испортиться, и Вы рискуете получить пищевое отравление.
- Сырые и готовые продукты обязательно нужно разделывать на разных досках и разными ножами. Даже если в сырой курице и живет какая-нибудь бактерия, она не выживет при варке или жарении. Но если на той же доске, где Вы разделывали курицу, сделать салат – все сальмонеллы с курицы окажутся в Вашей тарелке.
- Внимательно смотрите на сроки годности и условия хранения продуктов в магазинах. Если то же мясо хранится на витрине без охлаждения, на жаре, да еще и под солнцем – подумайте дважды и трижды, стоит ли Ваше здоровье того, чтобы им рисковать.
- Не покупайте продукты в магазине, где продавец на одних и тех же весах взвешивает кур и колбасу, то есть сырую и готовую продукцию. С курами ничего не случится, а вот такой колбасой очень легко отравиться.

- Если Вам показалось, что продукт подпорчен, а курица или мясо остались сырыми внутри – не ешьте. Выбросьте. Как бы ни было жалко.
- Мойте куриные яйца. Это очень важно. Причем мыть их нужно не непосредственно перед приготовлением, а сразу, как только Вы принесли их из магазина. И только потом уже закладывайте в холодильник на хранение. Часто бывают случаи, когда сальмонеллы заносятся на продукты вторично: остаются на полотенце для рук, лопаточке для готовки или на ноже, которым разбивали яйца. А итог все равно печальный.
- Не кормите маленьких детей яичницей. Заболевание опасно и протекает обычно достаточно тяжело. Не ешьте сырые яйца, если вы не уверены в их безопасности.
Как лечить сальмонеллез в домашних условиях народными средствами: диета и профилактика
Сальмонеллез относится к инфекционным заболеваниям, которое вызывает воспаление слизистой ЖКТ. Если своевременно не принимать меры, болезнь может протекать тяжело, приводя к опасным осложнениям.
Всегда следует знать, как лечить сальмонеллез в домашних условиях, какой должна быть диета и меры профилактики.
Упорядоченное питание помогает, вместе с использованием народных средств, быстрее восстановить организм, одновременно смягчая весьма неприятные симптомы этого заболевания.
Диета
Уже в самом начале заболевания возникает опасность обезвоживания организма.
Спустя пару дней можно переходить к максимально щадящему питанию.
Диета при сальмонеллезе у взрослых предусматривает употребление кисломолочных продуктов, а также некоторых фруктов, ягод и овощей. Все они помогают восстановить естественную микрофлору кишечника, одновременно угнетая развитие сальмонелл.
Фрукты с ягодами желательно употреблять в виде киселей и компотов, хотя можно и сырыми, а вот отварные овощи только в виде перетертого тщательно пюре. Выбирая в рацион плоды, следует предпочесть те, которые содержат много пектина. Это вещество деликатно, однако эффективно очищает от токсинов кишечник. Это способствует оздоровлению микрофлоры ЖКТ. Пюре, приготовленное из сырых бананов, моркови и яблок прекрасно усваивается, оно улучает состояние больного, поэтому такие блюда рекомендованы для употребления дома. Показано также картофельное пюре, сваренное на воде.
Можно немного употреблять хлеб, однако, лишь подсушенный и белый. Разрешены каши, приготовленные на воде:
- манная;
- гречневая;
- рисовая.
Каждое блюдо рациона необходимо запекать, отваривать или готовить на паровой бане, жареные продукты категорически запрещены. Также нельзя употреблять то, что способно раздражать ЖКТ:
- маринады;
- консервы;
- копчености;
- специи;
- полуфабрикаты.

Сахар способствует процессам брожения, поэтому его не следует употреблять. Также нежелательны груши, сливы и виноград, поскольку их шкурки тяжело перевариваются. Откажитесь от цитрусовых, бобовых культур и огурцов.
Рыбу и нежирное мясо нужно постепенно добавлять к рациону в виде фрикаделек и паровых котлет. Дробное питание минимально нагружает ЭКТ, поэтому питаться необходимо часто, однако понемногу.
Даже после нормализации состояния и исчезновения неприятных симптомов, чтобы не допустить повторное заражение лучше не прекращать диету. Взрослым необходимо придерживаться такого рациона хотя бы еще месяц после окончательного выздоровления.
Народное лечение
Хотя больных обычно помещают в больницу, однако как вспомогательный способ помочь себе можно порекомендовать лечение сальмонеллеза народными средствами. Не забывайте, что одобрение на их применение нужно получить у врача.
Публикуем несколько рецептов, помогающих при наличии легкой формы сальмонеллеза у взрослых.
Ромашка и календула
С давних времен ромашка с календулой помогают людям бороться с различными кишечными инфекциями, среди которых и сальмонеллез. Для преодоления недуга следует приготовить:
- настой из цветков календулы – заварить чайную их ложку в стакане кипятка, а затем пить перед приемом пищи.
- настой из цветков ромашки готовят, добавляя их столовую ложку в стакан кипятка, а затем еще минут пять кипятят, процеживают и употребляют после еды по четверти стакана.
Подорожник и змеевик
Целебное действие оказывает настой подорожника. Его листья необходимо высушить, а затем измельчить. Высыпать ложку зелья в стакан с кипятком, настоять 10 минут. Затем выпить мелкими глотками за час.
Полезно также съедать трижды в сутки змеиный горец (змеевик) по столовой ложке. Это средство применяется при разных заболеваниях ЖКТ.
Черемуха и земляника
Лесная земляника — полезная ягода.
Она помогает победить сальмонеллез. Необходимо залить столовую ложку листьев двумя стаканами холодной воды и оставить настаиваться на ночь. После процедить и выпить за день, каждый раз по полстакана.
Целебный настой получается из ягод черемухи. Ложку плодов бросить в стакан с кипятком, поставить на водяную баню. Спустя треть часа снять, отцедить и охладить. Употреблять по половинке стакана за полчаса перед едой.
Грецкий орех и кровохлебка
Отвар из корней растения кровохлебка помогает при сальмонеллезе. Корни растения следует мелко нарезать, набрать столовую ложку и залить стаканом кипятка. Поставить на небольшое пламя и полчаса кипятить. Затем охладить, процедить. Пить с промежутками целый день по столовой ложке.
Вяжущим действием отличается грецкий орех. Расколоть 200 г орехов, вынуть перегородки. Залить их стаканом спирта и выдержать пару дней. Настойку принимать по 9 капель трижды за день, разводя ее кипяченой водой.
Сальмонеллез у детей
У ребенка инкубационный период болезни длится около трех дней.
Симптомы зависят от возраста. Самое сложное течение сальмонеллеза наблюдается у грудничков.
С первых дней при сальмонеллезе ярко выражены такие признаки интоксикации:
- повышение температуры;
- нежелание кушать;
- плач;
- слабость.
Через три дня появляется понос. Испражнения водянистые, зеленоватые. Спустя неделю в кале заметны прожилки крови.
При детском сальмонеллезе лечение в домашних условиях лучше не проводить, необходимо срочно везти малютку в больницу. До прибытия врачей малыша необходимо обильно поить и оградить других детей от контактов с ним.
Профилактика
Для предупреждения такого заболевания, как сальмонеллез профилактика в домашних условиях должна быть направлена на правильную обработку пищевых продуктов, предупреждение распространения среди домашних питомцев возбудителей болезни, соблюдение режима санитарии.
Заключение
Народные методы лечения сальмонеллеза желательно применять только по советам доктора.
Иначе можно лишь ухудшить состояние, а не излечиться.
Чтобы предотвратить заболевание, а если оно уже появилось, успешно его вылечить, не обойтись без помощи врача-инфекциониста. Рисковать беспричинно собственным здоровьем не стоит.
Видео: Симптомы и лечение сальмонеллеза — Доктор Комаровский
Эти материалы будут вам интересны:
Похожие статьи:
- Как вывести вшей при помощи народных средств? Заметив, что ваш ребенок слишком часто и активно чешет голову…
- Лечение кашля в домашних условиях: 5 лучших народных средств Кашель – сам по себе не болезнь, а один из…
- Коньюктивит — лечение в домашних условиях: 11 лучших народных средств Если у вас слезятся глаза, и вы ощущаете жжение, то…
11 способов профилактики салмонеллеза.
com | CleanipediaСальмонеллез: симптомы и профилактика
Сальмонелла может вызывать сильное пищевое отравление. Для такого заболевания свойственны следующие симптомы:
сильная диарея, которая сопровождается режущей болью в области живота, метеоризмом. Позывы к опустошению кишечника могут повторяться до 10 раз в день и больше;
тошнота и частая рвота. Такое состояние может наблюдаться в течение нескольких дней даже при отсутствии какого-либо питания. Постепенно наступает сильное обезвоживание организма. В такой ситуации важно вовремя принять меры и предотвратить негативные последствия для организма;
полное отсутствие аппетита. В первые дни больной может употреблять только жидкость, чтобы восстановить водный баланс;
головные боли, повышенная температура, чувство озноба и ломоты в теле, состояние общей слабости.
Бактерии сальмонеллы часто обнаруживаются в пресных водоемах, преимущественно – в местах поселения водоплавающих птиц.
Не стоит недооценивать сальмонеллез: влияние на человека и профилактика данного заболевания беспокоят все мировое сообщество! Для собственной безопасности лучше избегать купания в озерах и прудах, которые не отмечены специальными знаками о допустимом использовании.
Бактерии сальмонеллы могут находиться в водоемах, особенно в местах обитания водоплавающих птиц. Потому избегайте купания в местах, не отмеченных, как безопасные, специальными знаками.
Сальмонеллез и продукты животного происхождения
Распространенными источниками сальмонелл могут оказаться пищевые продукты, люди и животные, которые являются носителями опасного заболевания. Меры профилактики сальмонеллеза – какие продукты нужно употреблять с большой осторожностью:
Мясо в сыром виде или без достаточной тепловой обработки (с кровью).
Птица.
Куриные и утиные яйца.
Молоко, которое не прошло процесс пастеризации.
Десерты с кремом.

В отличие от банального пищевого отравления сальмонеллез труднее обнаружить на ранних этапах. Довольно часто болезнь путают с другими недомоганиями в детском возрасте. Потому особенное внимание стоит уделить профилактическим мерам.
Болезнь сальмонеллез: профилактика по пунктам
Не нужно отказываться от потребления продуктов животного происхождения из-за страха заразиться сальмонеллезом. Чтобы защитить себя и членов своей семьи – важно соблюдать некоторые правила, которые относятся к гигиене и приготовлению домашней пищи. Основные моменты профилактики сальмонеллеза в домашних условиях:
Тщательно мойте руки перед процессом приготовления и употребления пищи, после любой прогулки и туалета. Постоянно напоминайте детям о необходимости такого мытья.
Проводите дезинфекцию туалета при помощи хлорсодержащих чистящих средств (например, универсальных гелей Domestos). Перед применением нового продукта внимательно изучайте инструкцию, оптимальный вариант – проверить работу средства на небольшом участке (чтобы не повредить покрытие).

Не приобретайте мясо, птицу, яйца и молочные продукты, которые не имеют пометки о прохождении ветеринарного контроля.
Используйте специальные разделочные доски, молотки, ножи и вспомогательные инструменты для мяса и птицы. Часто дезинфицируйте рабочую поверхность.
Исключите из меню яйца, которые не прошли термообработку.
Не стоит оставлять приготовленные блюда с мясом при комнатных условиях более 2 часов.
Если готовые продукты хранились более 24 часов – используйте повторную термообработку.
Кипятите молоко, которое не прошло стандартную пастеризацию.
При наличии маленьких детей в обязательном порядке обрабатывайте все поверхности антибактериальными средствами (например,Glorix).
Готовьте блюда для одного приема пищи.
Не храните сырое мясо или птицу рядом с другими продуктами в холодильнике.
Основа профилактики сальмонеллеза у людей – соблюдение технологий приготовления пищевых продуктов, достаточная термообработка мяса, яиц, молока
Сальмонеллез: важные моменты
Инкубационный период сальмонеллы составляет 4-7 суток.
В течение этого промежутка времени возникают первые отличительные признаки отравления. Сальмонеллез у маленьких детей провоцирует сильное беспокойство, проблемы со сном, частый стул и рвоту. Лечение сальмонеллеза в детском возрасте гораздо труднее, чем у взрослого – поэтому необходимо как можно быстрее обратиться к врачу.
При появлении первых подозрений на отравление больного нужно быстро изолировать от других членов семьи – кишечные инфекции чрезвычайно быстро распространяются. Особую опасность для окружающих людей составляет инфицированный человек, который взаимодействует с пищевыми продуктами (приготовление, торговля). Когда у зараженного сальмонеллезом исчезают основные симптомы заболевания – это не является признаком окончательного выздоровления, человек продолжает выделять возбудителей. В подобной ситуации он выступает носителем и распространителем сальмонеллеза. Особенно, если особа не подозревает о болезни и мерах предосторожности.
Признаки пищевого отравления – достаточная причина для немедленного обращения к врачу.
Быстрое реагирование на болезнь поможет избежать потенциальных осложнений и большого вреда для здоровья. В целях профилактики регулярно мойте руки и приучайте детей к соблюдению правил гигиены. Не забывайте о регулярной бактерицидной обработке кухонных поверхностей и ванной комнаты. Старайтесь соблюдать технологию приготовления блюд и правила хранения пищи.
Сальмонеллез считается серьезным заболеванием, которое не имеет специфической профилактики. Чтобы сохранить собственное здоровье – придерживайтесь общих правил гигиены, приготовления и употребления пищи, избегайте купания в неизвестных водоемах. Уделяйте особое внимание гигиене детей, поскольку они относятся к группе риска данного заболевания. Особенности лечения и выздоровления сальмонеллеза напрямую зависят от скорости обращения к врачу!
Всегда мойте руки перед контактом с пищей и после посещения туалета.
Приучите детей тщательно соблюдать меры личной гигиены.
Проводите регулярную антибактериальную обработки кухонных поверхностей, санузлов и пола.

Покупайте продукты только в проверенных торговых точках.
Не оставляйте готовую пищу при комнатной температуре.
Соблюдайте технологию приготовления пищи и хранения пищевых продуктов.
Сальмонеллез
Среди многочисленных инфекционных кишечных заболеваний одно из лидирующих мест занимает сальмонеллез.
Это острая инфекционная болезнь человека и животных, характеризующаяся преимущественным поражением желудочно-кишечного тракта. Возбудители – микроорганизмы принадлежащие к роду сальмонелл, получившие свае название по имени американского ветеринарного врача Сальмона. В настоящее время число выявленных представителей рода сальмонелл приближается к 2000. Они выделяются из кишечника больными животными, птицами и людьми.
Сальмонеллы – это мелкие бактерии, которые длительно сохраняют жизнеспособность в окружающей среде и пищевых продуктах и даже размножаются в них, не изменяя при этом внешний вид и вкус продукта.
При заражении продуктов они могут жить : в колбасных изделиях от 60 до 130 дней, в замороженном мясе, сырых яйцах от 6 до 13 месяцев, в яичном порошке до 9 месяцев, твердых сырах до 1 года, на замороженных овощах и фруктах от 2-х недель до 2,5 месяцев, в молоке до 20 дней.
В испражнениях животных они сохраняются до 4-х лет, в почве до 9 месяцев, воде открытых водоемов, питьевой воде они живут до 120 дней, в комнатной пыли -1,5 года. Употребление продуктов, воды, загрязненной фекалиями, как правило, служитпервопричиной заражения человека сальмонеллезом. Оптимальной температурой для размножения сальмонелл является 35-37 градусов (температура тела человека). При температуре 5градусов цельсии (температура холодильника) рост сальмонелл может прекращаться, но возбудитель хорошо сохраняется. Рост этих возбудителей могут подавлять или ограничивать высокие концентрации соли и сахара. При замораживании они сохраняются длительное время.
Источники и механизм заражения
Источником возбудителя инфекции для человека являются:
Больные сальмонеллезом люди илибактерионосители (внешне здоровые лица), которые выделяют во внешнюю среду возбудителя инфекции с фекалиями.
Больные сальмонеллезом животные, птицы или продукты их недоброкачественной переработки.
Заражение продуктов питания сальмонеллами происходит как при жизни животных, так и вследствие нарушения санитарно-ветеринарного режима убоя и обработки туш.
Заражение сальмонеллезом пищи может произойти как в домашних условиях, так и в предприятиях торговли, общественного питания, при транспортировке, при хранении с нарушением температурного режима ( при комнатной температуре количество сальмонелл в мясе через сутки увеличивается в 140 раз). Особенно быстро размножаются микробы в мясном фарше, недожаренных шашлыках, паштетах, винегретах, салатах.
Заражение воды открытых водоемов происходит в случае смывания в водоем, предназначенный для купания людей или водопотребления, особенно в период весеннего паводка, сточных вод от ферм и сельскохозяйственных угодий.
Заражение сальмонеллами яиц происходит от больной птицы, которая через желток может передавать потомству болезнь по наследству и при загрязнении скорлупы содержимым клоаки.
Употребление сырых яиц , яичницы-глазуньи и кремовых изделий из таких яиц приводят нередко к тяжелейшим пищевым отравлениям.
Заражение в домашних условиях – происходит при :
— нарушении технологии приготовления пищи,
— несоблюдении правил личной гигиены,
— при несоблюдении надлежащих условий и сроков хранения продуктов,
Невымытые руки человека после посещения туалета очень часто являются причиной заболеваний сальмонеллезом, т.к. возбудители могут быть внесены в пищевые продукты, на поверхность посуды, дверных ручек и т.д.
Восприимчивы к сальмонеллезу взрослые и особенно дети, которые могут заражаться от родителей, других лиц, ухаживающих за ними. Дети могут передавать инфекцию друг другу через руки, игрушки и другие предметы.
Заражение в общественных местах. Работники торговли, общественного питания, посторонние лица, привлекаемые для приготовления пищи в случаях семейных торжеств могут быть источником возникновения инфекции у значительного количества людей.
В случае нарушения правил термической обработки пищи, отсутствия достаточного количества холодильного оборудования для хранения большого количества скоропортящихся продуктов, нарушения сроков хранения заранее приготовленных блюд, правил товарного соседства и др.
Течение болезни
Заболевание, как правило, начинается через 4-6 часов от момента заражения, иногда инкубационный период может длиться 1-3 суток.
Оно проявляется после кратковременного чувства дискомфорта, возникают рвота, схваткообразные боли в животе, у большинства больных водянистый понос со слизью зеленоватого цвета. Развитие заболевания сопровождается подъемом температуры до 38-39 градусов, ознобом. Головной болью, болями в мышцах и суставах. Иногда течение сальмонеллеза напоминает грипп: озноб, температура, краснота в горле, кашель.
Лечение сальмонеллеза
При появлении первых признаков кишечного заболевания необходимо немедленно обратиться к врачу и рассказать ему что было съедено, выпито накануне или с кем больной общался в ближайшие 2-3 дня.
Самолечение недопустимо. Только врач с помощью лабораторных исследований может поставить правильный диагноз, назначить необходимое лечение и предотвратить осложнение заболевания.
Меры профилактики и защиты от сальмонеллеза
Чтобы уберечь себя от заболевания, необходимо помнить:
Продукты — всегда подвергать достаточной термической обработке. Исключить подогревание пищи, предпочитать кипячение. Продукты животного происхождения надо тщательно проваривать в течение часа или прожаривать. Куски мяса должны быть не толще 8-10 см. так как в более толстых кусках сальмонеллы при недостаточном кипячении выживают.
Скоропортящиеся пищевые продукты особенно в теплый период, следует готовить только в количестве, необходимом для текущего потребления. Готовую пищу тщательно оберегать от любого загрязнения, так как на руках, столах, инвентаре, используемом для обработки продуктов, могут находиться сальмонеллы.
Сырые мясные, рыбные продукты, яйца – необходимо хранить в холодильнике отдельно от готовых блюд и других продуктов.
Мясные, рыбные продукты заворачивать в пергамент,алюминиевую фольгу, полиэтиленовые пакеты, предназначенные для пищевых продуктов или помещать в стеклянную, эмалированную посуду. В холодильнике не должны лежать испорченные припасы.
Мороженое мясо – следует оттаивать не в воде , а исключительно в холодильнике, на нижней полке (сок мяса не должен капать на другие продукты). Исключить из меню – бутерброды с сырым мясом, не пробовать сырой фарш. Яйца и тушки птиц – мыть под проточной водой, после чего мыть руки с мылом, варить яйца не менее 10 минут. Внимательно и тщательно – готовить шашлыки, особенно из мяса птицы. Пользоваться – разными разделочными досками и ножами для обработки сырых и готовых продуктов. После разделки мяса необходимо тщательно вымыть и обдать кипятком инвентарь и посуду. Содержать в чистоте – все кухонные поверхности и одежду, в которой обычно осуществляется приготовление пищи.
Помните! Соблюдение этих правил предохранит Вас и ваших близких от заболевания сальмонеллезом и сохранит здоровье на долгие годы!
Государственное учреждение «Минский городской центр гигиены и эпидемиологии»
Сальмонеллезные инфекции — острые кишечные инфекции, которые вызываются различными видами микробов из рода сальмонелл и протекают в форме острых и затяжных желудочно-кишечных заболеваний.
Этиология. Регистрируется это заболевание повсеместно, в том числе и в высокоразвитых странах. Причина тому, широкое распространение среди сельскохозяйственных животных и домашних птиц, интенсификация животноводства и птицеводства на промышленной основе.
Возбудителями сальмонеллеза являются бактерии, которые называются сальмонеллами. У человека выделено более 700 их разновидностей.
Возбудители сальмонеллеза долго сохраняются во внешней среде: в молоке до 20 дней, в кефире до 2 месяцев, в мясе и колбасных изделиях от 2 до 4 месяцев, в сливочном масле до 4 месяцев, в воде до 5 месяцев, в замороженном мясе около 6 месяцев, в тушках птиц более года, в сырах до 1 года, в почве до 18 месяцев.
В некоторых продуктах (молоке, мясных изделиях) возбудители сальмонеллеза способны не только сохраняться, но и размножаться, не изменяя внешнего вида и вкуса продуктов.
Молоко больных коров содержит сальмонеллы, но в молоко здоровых коров микробы могут быть занесены руками доярок.
Кипяченое молоко безопасно. Длительно (несколько месяцев) сальмонеллы способны сохраняться жизнеспособными в сливочном масле. Продолжительный срок сальмонеллы живут во внешней природной среде: в почве, навозе, в загрязненной органическими веществами воде.
Соление и копчение оказывают на них очень слабое влияние, а замораживание даже увеличивает сроки выживания микробов в продуктах. Зараженное мясо, даже хранимое в холодильнике, не освобождается от сальмонелл. Последние могут сохраняться даже во льду.
Только высокие температуры, начиная с 80°С, и кипячение (100°С) губительно действуют на сальмонелл. Из этого следует важное требование к правильной кулинарной термической обработке мяса и других мясных продуктов.
Эпидемиология. Основной их источник — животные и продукты животноводства (мясо, молоко), птицы (птичье мясо, яйца, особенно утиные), человек же (больной и бактерионоситель) источник дополнительный
Возникновение сальмонеллезов в основном связано с зараженными мясными продуктами питания (пищевой путь передачи инфекции).
Однако существуют и другие продукты (молоко, масло, овощи, фрукты), которые, будучи вторично инфицированными, тоже могут стать дополнительным фактором заражения человека.
Накапливаясь в организме животных в огромном количестве, сальмонеллы током крови заносятся из кишечника в мышцы, различные внутренние органы, даже в костный мозг.
Здоровые животные заражаются от больных в различных условиях в результате тесного контакта. Это происходит в хлеву, коровнике, на выгонах, при транспортировке животных в вагонах, на пути к бойне. Заражаются они через испражнения, особенно если ими загрязняется корм. В связи с этим на бойнях и мясоперерабатывающих предприятиях животные и мясо подвергаются проверке в соответствии с существующими ветеринарными и санитарными правилами.
Передача инфекции от человека к человеку (контактно-бытовой путь передачи инфекции) встречается реже, но тоже вероятна. С первого же дня болезни испражнения, моча, рвотные массы, даже слюна и мокрота больных являются заразными.
При этом выделениями больных заражаются руки ухаживающих за ними людей, а через загрязненные руки обсеменяются микробами продукты питания и различные предметы домашнего обихода.
Бактерионосителями люди часто становятся после перенесения сальмонеллеза, независимо от тяжести течения заболевания. Бывает, что человек становится бактерионосителем даже после перенесения стертых, бессимптомных форм сальмонеллеза. Человеку, ставшему по той или иной причине бактерионосителем, надо знать, что носительство может быть различной длительности. Известны случаи многолетнего носительства сальмонелл.
Особенно надо подчеркнуть роль бактерионосителей, работающих в пищевой промышленности, магазинах, торгующих продовольственными товарами (продавцы мяса, молочных продуктов, колбасных изделий). Опасны носители сальмонелл, работающие в детских учреждениях.
Выявление носителей, отстранение их от работы в таких учреждениях, санация (оздоровление) до полной ликвидации носительства обязательны.
Заболеваемость сальмонеллезами регистрируется во все сезоны года с увеличением уровня в весеннее-летний период. Чаще сальмонеллезом болеют дети в возрасте до 6 лет и взрослые.
Клиника. Инкубационный период при сальмонеллезах (время от момента заражения до первых клинических проявлений заболевания) зависит от обилия обсемененности пищи микробами. Чем больше пища загрязнена микробами, тем скорее вырабатываются и начинают всасываться в кровь токсины. Это может быть от нескольких часов до одних-двух суток после приема пищи.
При заболевании сальмонеллезом больной жалуется на повышение температуры тела, боли в животе, жидкий и водянистый стул темно-зеленого цвета, озноб, головная боль, тошнота и рвота. У человека сальмонеллез нередко протекает тяжело. Тогда заболевание начинается с высокой температуры (39—40°С), сильной головной боли, общей слабости. Как следствие отравления микробными токсинами, возникают тошноты, рвоты, нередко понос. Осложнениями заболевания при тяжелом течении болезни могут быть сосудистый коллапс, гиповолемический шок, острая сердечная и почечная недостаточность, гнойные эритриты, эндокардиты, абсцессы мозга, селезенки и печени, а также перитониты и пневмония.
Профилактика и противоэпидемические мероприятия. При сальмонеллезах решающее значение имеет организация совместного надзора санитарно-ветеринарной и санитарно-эпидемиологической служб.
Санитарно-ветеринарная служба ведет постоянное наблюдение за заболеваемостью животных сальмонеллезом, а также частотой и характеристикой выделяемых сальмонелл от животных, из корма для них и т. п. Контролирует убой домашних животных и птиц (отбор животных для убоя, соблюдение технологии убоя). Особенно большое значение имеет контроль за эпизоотическим состоянием животноводческих, включая свиноводческие, комплексов, а также продукцией, исходящей из этих комплексов (мясо, в том числе птиц, яйца), поскольку возможность развития эпизоотии в них особенно велика. В тех случаях, когда создается угроза развития эпизоотии сальмонеллезов, проводятся соответствующие меры (изоляция больных животных, очистка и дезинфекция помещений для скота и птиц или даже уничтожение последних, изъятие контаминированного корма и т.
п.).
Санитарно-эпидемиологическая служба ведет наблюдение за заболеваемостью людей сальмонеллезом (ее уровень, динамика, возрастная структура), за характеристикой выделяемых сальмонелл от людей и из продуктов, поступающих на питание людей. Надзор предусматривает контроль за соблюдением санитарно-эпидемиологического режима в объектах общественного питания, технологического режима приготовления продуктов и блюд.
Для личной профилактики сальмонеллеза необходимо строго соблюдать следующие правила:
Скоропортящиеся продукты следует хранить в холодильнике
Сырые продукты и готовую пищу следует обрабатывать раздельно
Термическая обработка пищи должна быть достаточной
Нельзя есть сырые или недоваренные яйца.
И конечно же, необходимо соблюдать правила личной гигиены.
Внимание, сальмонеллез! Чем опасны перепелиные яйца и водные черепахи?
Внимание, сальмонеллез! Чем опасны перепелиные яйца и водные черепахи?
Ежегодно сальмонеллезом заболевают около 33 тысяч россиян, в их числе около 17 тысяч детей
Сальмонелла широко распространена среди домашних и диких животных, преимущественно среди животных, используемых в пищу, таких как домашняя птица, свиньи и крупный рогатый скот; и среди домашних животных, включая кошек и собак, птиц и рептилий, таких как черепахи.
В последние годы участились случаи заражения сальмонеллезом в результате контакта
с водными черепахами.Маленькие черепашки часто приобретаются в качестве домашних питомцев или обитателей живых уголков в школе. Следует знать, что сальмонеллы являются частью нормальной микрофлоры кишечника черепах, они присутствуют в помете, воде аквариума. После любого контакта с черепахой или местом ее обитания необходимо тщательно мыть руки, иначе, заражения не избежать.
Укоренилось мнение, что можно без опасений употреблять в пищу сырые перепелиные яйца, так как перепела не болеют сальмонеллёзом.Сторонники этой теории ссылаются на то, что перепелкам свойственна высокая температура тела ( 42 С), при которой сальмонеллы не размножаются. Действительно, перепелки не болеют сальмонеллезом, но являются носителями и распространителями сальмонелл, и могут стать источником заражения. Поэтому употреблять перепелиные яйца без соответствующей термической обработки недопустимо.
Как происходит заражение?
Заражение происходит во время приёма пищи, приготовленной без соблюдения правил термообработки. Человек может заразиться при употреблении сырой воды, во время ухода за животными, при работе на мясокомбинатах, употреблении в пищу инфицированных мяса или молочных продуктов. Птицы — самые активные разносчики сальмонелл, человек может заразиться, употребляя в пищу заражённое мясо, яйца или продукты, загрязнённые помётом больных птиц.
Высока вероятность заразиться от человека (больного или носителя) в детских садах, школах, больницах. Заражение контактно-бытовым путём происходит через бытовые предметы, горшки, бельё, полотенца, игрушки, не мытые руки больного человека, в том числе медперсонала или членов семьи, медицинские инструменты и оборудование (зонды, катетеры), не обработанные по всем правилам стерилизации.
Наиболее подвержены заражению сальмонеллезом дети, пожилые люди, люди, у которых по той или иной причине снижен иммунитет, работники птицефабрик и животноводческих ферм, люди, увлекающиеся сыроедением, люди, пренебрегающие правилами личной гигиены и термической обработки продуктов.
Как протекает болезнь?
Для сальмонеллеза характерно резкое повышение температуры, боль в области живота, диарея, тошнота и иногда рвота. Симптомы болезни появляются через 6-72 часа (обычно через 12-36 часов) после того, как бактерия оказалась в организме. Болезнь длится от 2 до 7 дней.
Заболевание протекает обычно относительно легко, В большинстве случаев выздоровление наступает без специального лечения. В более тяжелых случаях — проводится симптоматическое лечение, восполнение электролитов и потерянной жидкости.
Правила индивидуальной профилактики сальмонеллеза
- Тщательно мыть руки с мылом (особенно после посещения уборной и перед едой).
- Не приобретать мясо, мясные изделия, птицу, яйца , творог, молоко, масло, сыр в местах несанкционированной торговли.
- Приобретая яйца, строго следить за датой сортировки ( она указывается как на упаковке, так и непосредственно на яйцах). Допустимый срок реализации- 25 дней.

- Приобретая продукты на рынке или в магазине, следует следить за соблюдением товарного соседства продуктов. Сырая и готовая продукция обязательно должна находиться на отдельных витринах и продаваться разными людьми.
- В домашних условиях соблюдать правила хранения продуктов (сырые продукты и готовая еда должны храниться отдельно).
- Регулярно мойте холодильник, тщательно очищая ячейки для хранения яиц.
- Выделите отдельные разделочные доски для сырых и готовых продуктов.
- Тщательно мойте и ошпаривайте кипятком кухонную утварь.
- Яйца следует варить не менее 10 минут с момента закипания, птицу — 40 минут, мясо — не менее 2 часов.
- Никогда не снимайте пробу с сырого мясного фарша.
- Не пейте сырое молоко;
- Хорошо промывайте под проточной, а затем кипячёной водой фрукты, зелень и овощи. Оптимально- ошпаривать кипятком.
- В процессе приготовления пищи мойте руки после разделки сырого мяса, рыбы, птицы, контакта с сырыми яйцами.

Помните: специфической профилактики сальмонеллёза у человека не существует.
Берегите здоровье, осмотрительно подходите к питанию и тщательно следите за гигиеной.
Руководство по лечению заболеваний доктора Вейла
- Домой
- Здоровье и благополучие
- Тело, разум и дух
- Насекомые и паразиты
Что такое сальмонеллез?
Заражение бактериями сальмонеллы является основной причиной пищевых отравлений в США и Европе. Центры по контролю за заболеваниями США определяют сальмонеллез, в основном от яиц, как важную проблему общественного здравоохранения, по оценкам, ежегодно регистрируется более 100 000 случаев.
Поскольку многие более легкие случаи не диагностируются и не регистрируются, фактическое число инфекций может быть в 30 и более раз больше. Инфекции чаще встречаются в теплое время года и поражают детей больше, чем взрослых.
Каковы симптомы?
Симптомы включают лихорадку, спазмы в животе, тошноту, диарею и рвоту, которые начинаются через 12–72 часа после приема зараженной пищи. Болезнь может длиться от четырех до семи дней. Хотя большинство людей выздоравливают без лечения антибиотиками, тем, у кого развилась тяжелая диарея, могут потребоваться антибиотики и госпитализация из-за обезвоживания.В тяжелых случаях бактерии попадают в кровоток и могут вызывать инфекции в отдаленных участках тела. Болезнь имеет тенденцию быть наиболее серьезной у пожилых людей, младенцев и людей с ослабленной иммунной системой.
Каковы причины?
Два наиболее распространенных типа сальмонеллеза в Соединенных Штатах происходят от Salmonella typhimurium и Salmonella enteritidis.
Вы можете заразиться сальмонеллезом, употребляя в пищу продукты, зараженные бактериями, что может произойти во время обработки или обработки пищевых продуктов, особенно если обработчики не моют руки после посещения туалета.Сальмонеллу также можно обнаружить в фекалиях некоторых домашних животных, особенно тех, у кого диарея. Заражение может произойти, если вы вступаете в контакт с фекалиями домашних животных без надлежащего мытья рук.
Рептилии, цыплята и утята, а также мелкие грызуны, такие как хомяки, особенно часто переносят сальмонеллу на своей коже или панцире (особенно черепахи). Взрослые и дети всегда должны хорошо мыть руки сразу после контакта с любым из этих животных, даже если они кажутся здоровыми.
Продукты, которые обычно содержат сальмонеллу, — это сырая говядина, птица, непастеризованное молоко и яйца, а также овощи.Загрязненная пища обычно выглядит и пахнет нормально.
Что такое традиционное лечение?
Инфекции Salmonella обычно проходят через пять-семь дней и часто не требуют лечения, кроме ротовых жидкостей.
Рекомендуются частые глотки восполняющего электролиты напитка (например, Pedialyte) — выпивайте от шести до восьми унций за каждый больший стул. Некоторые врачи рекомендуют более мягкую диету, состоящую из бульонов (таких как куриный суп), тостов, пасты, бананов и яблочного пюре.Тем не менее, недостаточно исследований, чтобы предположить, что эта ограниченная диета значительно лучше или с большей вероятностью ускорит выздоровление, чем любая другая в целом сбалансированная диета. Постарайтесь исключить продукты с высоким содержанием жира и сахара в течение этого времени, а также избегайте острой пищи, алкоголя и кофе, пока симптомы присутствуют, и по крайней мере в течение двух дней после этого.
Людям с тяжелой диареей может потребоваться госпитализация и регидратация внутривенными жидкостями. Антибиотики, такие как ампициллин, триметоприм-сульфаметоксазол или ципрофлоксацин, могут на самом деле продлевать инфекцию и обычно не нужны, если только бактерии не распространяются из кишечника в кровь или если не замечено появление крови в стуле.
Некоторые бактерий Salmonella стали устойчивыми к антибиотикам, в основном в результате крупномасштабного коммерческого использования антибиотиков в кормах для животных.
Какие методы лечения сальмонеллеза рекомендует д-р Вейл?
Относительно мало что можно сделать для ускорения заживления после проявления заболевания, поэтому профилактика является ключевым фактором. Чтобы предотвратить заражение сальмонеллезом от яиц — распространенного переносчика — помните, что эта бактерия попадает в яйца еще до того, как сформируется скорлупа, внедряясь в яичники здоровых на вид куриц.Глядя на яйцо, вы не можете сказать, заражено оно или нет, но вы можете уничтожить бактерии и предотвратить заболевание, если будете правильно обращаться с яйцами и готовить их, а это означает:
- Покупайте яйца только в холодильнике и храните их в холодильнике, как только принесете домой. Используйте яйца в течение трех недель после покупки.
- Готовьте яйца, пока желток и белок не станут твердыми.
Этого легче добиться, «взбивая» яйца, а не готовя их «солнечной стороной вверх» или «слишком легко».«Удостоверьтесь, что все продукты, содержащие яйца, приготовлены до 160 градусов. - Подавайте вареные яйца и блюда, содержащие яйца, сразу после приготовления. Охладите яйца, сваренные вкрутую, через два часа (независимо от того, находятся ли они в скорлупе или были очищены) и охлаждайте все продукты, содержащие яйца. Съешьте все продукты, содержащие вареные яйца, в течение четырех дней.
- Для заправки для салата «Цезарь», тирамису, домашнего мороженого, майонеза, теста для печенья, глазури и других блюд, требующих сырых яиц, используйте только пастеризованные яйца, прошедшие термическую обработку для уничтожения сальмонеллы.Пастеризация яиц убивает бактерии, но тепла недостаточно для приготовления яиц. Картонные коробки, содержащие эти яйца, должны иметь четкую маркировку.
Готовьте мясо до полной готовности. Используйте термометр для мяса, чтобы быть уверенным, что мясо приготовлено до внутренней температуры не менее 160 градусов по Фаренгейту.
Не используйте цвет мяса (например, когда оно больше не «розовое»), чтобы сказать вам, что оно готово. После работы с сырым мясом или другими продуктами животного происхождения обязательно тщательно мойте руки горячей водой вместе со всеми режущими поверхностями и посудой, чтобы избежать переноса бактерий с одного вида пищи на другой.Будьте особенно осторожны с деревянными разделочными досками, которые лучше впитывают влагу, чем пластиковые.
Избегайте сырого или непастеризованного молока, сыра или других молочных продуктов. Любые продукты, даже органические, могут содержать бактерии, поэтому обязательно очищайте те фрукты и овощи, которые можно очистить, и мойте остальные перед едой. Используйте небольшое количество разбавленного моющего средства для посуды и скребка для овощей, а затем промойте теплой водой, чтобы удалить остатки и любой пищевой воск.
При приеме пищи в салат-баре убедитесь, что овощи хорошо охлаждены (хранятся на льду) и что еда надлежащим образом защищена защитой от чихания или капюшоном.
Избегайте вещей, которые выглядят старыми или высохшими.
Не передавайте еду или воду другим, если у вас активная инфекция сальмонеллы, и не забывайте всегда мыть руки после контакта с фекалиями животных. Поскольку рептилии особенно часто являются переносчиками бактерий сальмонеллы, мойте руки сразу же после контакта с ними. Подумайте о том, чтобы не заводить рептилий (включая черепах) в качестве домашних животных, особенно если с вами живут маленькие дети, младенец или пожилой человек.
Наконец, будьте в курсе вспышек сальмонеллеза.На веб-сайте Центров по контролю за заболеваниями (CDC) перечислены все зарегистрированные или предполагаемые вспышки и затронутые географические районы. В нем также перечислены отзывы о зараженных продуктах питания и пищевых продуктах.
Профилактика сальмонеллеза — Департамент здравоохранения Миннесоты
Минимизация риска
Мойте руки
- Мойте руки после посещения туалета и смены подгузников, а также перед
обрабатывать или есть любую пищу.

- Убедитесь, что больные диареей, особенно дети, моют свои руки осторожно и часто с мылом, чтобы уменьшить риск распространения инфекция.
- Всегда мойте руки после контакта с сельскохозяйственными животными, домашними животными, фекалиями животных, и среды обитания животных.
- Рука
Гигиена
Помой свои руки!
Поддерживайте чистоту в местах приготовления пищи
- Храните сырое мясо и птицу отдельно от продуктов и других пищевых продуктов, когда покупка и хранение продуктов.
- Мойте руки, разделочные доски, столешницы, столовые приборы и посуду после обращение с сырой птицей.
- Мойте сырые фрукты и овощи перед едой.
- Перекрестное загрязнение
Пищевые и кухонные инструменты и поверхности могут быть загрязнены сырыми продукты питания.
Избегайте непастеризованных продуктов
- Избегайте непастеризованного (сырого) молока и продуктов, приготовленных из непастеризованного молока
Готовьте и храните пищу в соответствующих температуры
- Не ешьте сырые или недоваренные яйца.Используйте пастеризованные яйца при приготовлении блюда, не требующие приготовления, такие как голландский соус, салат соусом, сырыми пирогами или домашним мороженым.
- Тщательно готовьте сырое мясо и птицу, чтобы уничтожить бактерии. Мясо, домашняя птица и гамбургеры должны быть приготовлены до тех пор, пока они не перестанут быть розовыми в центре.
- Хранение
и температуры приготовления
Узнайте больше о температурах хранения и приготовления - Размораживайте продукты в холодильнике, в холодной воде или в микроволновой печи.
Пищу следует хранить в холодильнике при температуре 40°F или ниже.
морозильная камера с температурой 0°F или ниже.
Будьте осторожны при обращении с животными
- Всегда мойте руки после контакта с сельскохозяйственными животными, домашними животными, фекалиями животных, и среды обитания животных.
- Свести к минимуму контакт с животными с диарейными заболеваниями.
- Не принимайте пищу в местах, где присутствуют животные.
- Заболевание кишечника, полученное от животных
Еще о болезнях и животных:
Будьте осторожны при плавании
- Не глотайте воду из озера или бассейна во время плавания.
- Всем, у кого диарея, следует избегать плавания в общественных бассейнах.
или озера, купаясь вместе с другими и готовя еду для других.

- CDC: здоровое плавание
CDC; Содержит информацию о заболеваниях, передающихся через воду.
Подозреваете ли вы, что у вас болезнь пищевого или водного происхождения? Посещение с сообщением о подозрении на болезни пищевого/водного происхождения.
Защитите себя от сальмонеллы и кишечной палочки естественным путем
Делиться заботой!
Кажется, что каждый раз, когда вы включаете новости, происходит очередной отзыв еды. Если вы посмотрите список отзыва пищевых продуктов FDA, вы увидите буквально десятки продуктов, перечисленных в любой момент времени. Большие сборища, на которых еда задерживается на несколько часов — например, общие обеды — часто заканчиваются тем, что люди заболевают от той или иной степени пищевого отравления.Есть способы, которыми вы можете помочь защитить себя от сальмонеллы и кишечной палочки естественным путем.
Примечание.
Эта статья содержит советы по общей безопасности пищевых продуктов и укреплению иммунной системы. Он предназначен только для общих информационных целей.
Если вы испытываете сильную боль, рвоту, диарею или другие осложнения, немедленно обратитесь к лечащему врачу! Я не врач, я только делюсь тем, что работает для меня и моей семьи.
Знай своих патогенов
Бактерии кишечной палочки (Escherichia coli) и сальмонеллы обычно обнаруживаются в пищеварительной системе человека и животных.
CDC утверждает, что:
«Большинство E. coli безвредны и на самом деле являются важной частью здорового желудочно-кишечного тракта человека. Однако некоторые E. coli являются патогенными, то есть они могут вызывать заболевания, будь то диарея или заболевания вне кишечного тракта».
Термин «сальмонелла» используется для обозначения примерно 2000 сходных типов бактерий, которые различаются по степени потенциального заболевания.
Как заразиться типами кишечной палочки или сальмонеллы, от которых мы заболеваем? Из ЦКЗ:
Сальмонелла«Виды E.coli , которая может вызывать диарею, может передаваться через загрязненную воду или пищу, а также при контакте с животными или людьми».
ведет себя аналогичным образом, поэтому мы видим вспышки заболеваний, связанные с отзывом продуктов.
По данным WebMD, рептилии, цыплята и утята, а также мелкие грызуны особенно часто являются переносчиками сальмонеллы. Тщательное мытье рук всегда должно следовать за обращением с этими видами животных.
Так почему же одни люди заболевают при контакте с вредными бактериями, а другие нет?
Если вы подвергаетесь воздействию очень большого количества патогена, ваши риски резко возрастают.Некоторые штаммы бактерий также более вирулентны, чем другие.
Люди с угнетенной или незрелой иммунной системой также подвержены большему риску, например, очень молодые, очень старые, а также те, кто уже имеет дело с болезнью или лечением, которое включает ослабление иммунной системы, например химиотерапией.
Теория биологического ландшафта против микробной теории болезней более подробно объясняется в Timeless Remedies, но в основном она сводится к вере в то, что восприимчивый организм заболевает, в то время как здоровый организм может сопротивляться болезни, даже при воздействии патогенов.
Я видел эффективность этой теории в своей семье.
Мы не очень часто болеем, а если и болеем, то обычно в незначительной степени. Мы по-прежнему всегда соблюдаем правила безопасности пищевых продуктов! (см. ниже)
Пищеварительная система, заполненная полезными бактериями , менее восприимчива к вредным бактериям. В статье «Что такое пробиотики» указано:
.- Пробиотики снижают уровень вредных бактерий, таких как кишечная палочка и сальмонелла, производя конечные продукты метаболизма, которые ингибируют их или противодействуют им.К таким соединениям относятся перекись водорода, молочная и уксусная кислоты.
** - Подавляющие уровни микробных патогенов: L. Acidophilus может ингибировать патогены за счет снижения рН в кишечнике. Производство органических кислот эффективно снижает рН кишечника до уровня, благоприятного для хороших бактерий и разрушительного для патогенов.
- Защита иммунной системы. Некоторые исследования (см. ссылку справа) показывают, что штаммы L. Bulgaricus и L. Casei действительно эффективны для выполнения этой функции.
- Предотвращение появления вредных грибков и паразитов: L. Acidophilus и B. Bifidus агрессивно прикрепляются к стенкам толстой кишки. При этом они могут ингибировать Candida albicans, бактерии и паразита Giardia lamblia.
- Снижение уровня токсичных побочных продуктов: вредные бактерии могут производить токсины, такие как индол, скатол и метан, из-за их метаболической реакции на определенные продукты. Уменьшение их количества может снизить уровень токсинов в толстой кишке.
Мясная промышленность начинает обращать на это внимание и внедряет пробиотики для цыплят и свиней, чтобы снизить заболеваемость сальмонеллой.
Введение пробиотиков до того, как вы заболеете
Несмотря на то, что я всегда употребляю пробиотики во время болезни, максимальная устойчивость к болезням пищевого происхождения достигается за счет постоянного употребления продуктов с живыми культурами.
Действительно, некоторые исследования показали, что введение определенных пробиотиков после того, как сальмонелла уже заразила организм, не улучшает заживление .
Чтобы ознакомиться с рецептами пробиотических продуктов, посетите раздел «Живые культуры/пробиотики/ферменты» на странице «Рецепты», а дополнительную информацию о роли пробиотиков в борьбе с болезнями можно найти в публикации «Подготовка к сезону простуды и гриппа – Шаг № 1- Пробиотики».
Что мне делать, если я уже болен?
***Если вы испытываете сильную боль, рвоту, диарею или другие осложнения, немедленно обратитесь к врачу! Я не врач, я только делюсь тем, что помогает мне и моей семье.
***
Если у вас есть симптомы типа желудочного гриппа и вы не уверены, является ли ваше заболевание вирусным или бактериальным по своей природе, вы можете ознакомиться с этой статьей о «желудочном гриппе». («Желудочный грипп» вызывается не вирусом гриппа, а другими семействами вирусов.)
Если вы знаете, что столкнулись с бактериальным заболеванием, в книге Herbal Antibiotics рекомендуется следующее:
Травы для лечения кишечной палочки – желтокорень, чеснок, эвкалипт, криптолепсис, можжевельник, акация, шалфей, имбирь, экстракт семян грейпфрута , экстракт семян грейпфрута, Terminalia spp., Punica spp.
Узнайте больше о растительных антибиотиках.
Общие рекомендации по предотвращению отравления сальмонеллой и кишечной палочкой
Salmonella.org дает следующие рекомендации Министерства сельского хозяйства США по предотвращению сальмонеллеза, которые также являются хорошими рекомендациями по предотвращению любого типа пищевого отравления:
- Часто мойте руки и поверхности
- Мойте руки, разделочные доски, посуду и т.
д. горячей мыльной водой перед тем, как прикасаться к пище. - Отделяйте сырое мясо, птицу и морепродукты от других продуктов в холодильнике.
- Готовить при надлежащей температуре, внутренняя температура не менее 160°F (72°C)
- Быстро охлаждать
Например, вы можете наполнить этот надувной салат-бар льдом, чтобы еда оставалась прохладной.
Я предпочитаю деревянные разделочные доски пластиковым, так как они обладают естественными антибактериальными свойствами.
Вы можете прочитать больше об антибактериальных свойствах деревянных разделочных досок, а также инструкции по уходу и дополнительные советы по безопасности пищевых продуктов на кухне в посте «Почему деревянные разделочные доски лучше всего».
Салат Ромейн вспоминает
Не ешьте сырую зелень, зараженную сальмонеллой или кишечной палочкой.
Источником бактерий является вода, которую они используют для полива растений, и НЕ МОЖЕТ СМЫВАТЬСЯ, так как она находится внутри растения.
Верните или выбросьте зелень и очистите места (например, ящик для овощей в холодильнике), к которым они прикасались.
ПРИМЕЧАНИЕ. Не компостируйте салат ромэн, зараженный кишечной палочкой. (O157:H7), если только у вас нет очень горячей компостной кучи.
В сообщении на Facebook от 21 ноября 2018 года Управление по переработке и отходам округа Центр Беллефонте, штат Пенсильвания, сообщает:
Для уничтожения определенного штамма кишечной палочки требуется температура 160 градусов по Фаренгейту в течение 10 дней. (O157:H7) в текущем заражении салата ромэн.
Несмотря на то, что процесс компостирования иногда достигает, а иногда и превышает температуру 155 градусов по Фаренгейту при методе компостирования в открытом валке, нет гарантии, что обработка будет достигать 160 градусов по Фаренгейту в течение полных 10 дней, особенно зимой.
Это коррелирует с результатами недавнего исследования, которые показывают, что некоторые E coli могут иметь повышенную термостойкость.
В статье «Говяжий фарш может нуждаться в более высокой температуре приготовления, чтобы быть безопасным» отмечается, что был обнаружен набор генов, который придает некоторым бактериям кишечной палочки повышенную термостойкость. Они называют это местом теплового сопротивления или LHR.
Приблизительно 2% как патогенных, так и непатогенных кишечных палочек несут этот генетический признак. Они все еще работают над обновлением правил приготовления пищи.
Для получения советов по безопасному домашнему консервированию посетите:
Если вы нашли этот пост полезным, поделитесь им.
Первоначально опубликовано в 2011 г., обновлено в 2018 г.
натуральных средств от пищевых отравлений, которые действительно работают
По данным Центров по контролю за заболеваниями (CDC), примерно 76 миллионов американцев ежегодно получают пищевые отравления. Несмотря на то, что у нас один из самых безопасных продуктов питания в мире, пищевое отравление в первую очередь вызывается неправильным и негигиеничным обращением с едой, что может привести к размножению и распространению вредных бактерий.
Многие тысячи случаев предполагаемого гриппа на самом деле являются случаями пищевого отравления с похожими симптомами.
Чтобы вызвать болезнь, требуется лишь микроскопическое количество бактерий. Практически каждый подвержен бактериальному пищевому отравлению, симптомы которого могут варьироваться от умеренного пищеварительного дискомфорта до летального исхода. К бактериям, вызывающим пищевое отравление, относятся сальмонелла, кампилобактер, кишечная палочка и некоторые другие патогены.
Болезнетворные бактерии чаще всего встречаются в мясе, морепродуктах и молочных продуктах, хотя мы также наблюдали вспышки заражения в салате, дынях и других фруктах и овощах, а также в ограниченном количестве упакованных и готовых пищевых продуктов.Эксперты считают, что болезнетворные бактерии никогда не могут быть полностью искоренены из пищевой цепи, и широко распространено мнение, что бактериальное загрязнение пищевых продуктов растет, что представляет серьезную угрозу для здоровья населения.
Еще от Fox: CDC сообщает о случаях использования испорченного сыра рикотта
Охлаждение пищи и ее правильное приготовление являются хорошо известными методами снижения вероятности бактериального пищевого отравления. Мытье рук и посуды с мылом и теплой водой также снижает риск.Кроме того, раздельное приготовление продуктов животного и неживотного происхождения может снизить вероятность перекрестного заражения — распространения бактерий из одного продукта в другой. Чтобы снизить вероятность загрязнения пищевых продуктов, ознакомьтесь с простыми советами по безопасности, которые можно найти в Интернете.
Но что, если, несмотря на все ваши усилия, вы все равно получите пищевое отравление? Есть некоторые природные средства, которые могут помочь.
Если вас немного тошнит, чашка или две крепкого чая из корня имбиря могут быть достаточными, чтобы предотвратить дальнейший дискомфорт.Имбирь богат мощными противовоспалительными соединениями, которые помогают подавить тошноту и желудочные расстройства.
Вы можете пить имбирный чай так часто, как вам нравится. Часто это помогает. Я рекомендую органический имбирный чай от Traditional Medicinals, который можно найти в любом магазине натуральных продуктов и во многих супермаркетах.
Еще от Fox: Рост числа смертей от рака поджелудочной железы
Если вы чувствуете, что вам становится хуже, пара капсул андрографиса — китайской травы — может остановить дальнейшее развитие болезни.От 300 до 500 миллиграммов андрографиса два раза в день могут облегчить симптомы. Nature’s Way, поставщик фитотерапии, производит хорошую стандартизированную добавку с экстрактом андрографиса.
Чтобы остановить диарею из-за пищевого отравления, несколько капель амазонской травы «кровь дракона» могут помочь замедлить все процессы и восстановить правильную работу кишечника. Кровь дракона, доступная в виде жидкости, широко используется в Южной Америке при диарее. Это также традиционное средство, которое назначают женщинам после родов, чтобы остановить любое внутреннее кровотечение.
Вы можете получить жидкую кровь дракона от Raintree Nutrition.
Если вы сильно заболели — с ознобом, лихорадкой и диареей — вам нужно активизировать действия. Без сомнения, позвоните своему врачу. Пищевое отравление может быть изнурительным, а в некоторых случаях и смертельным. Когда становится совсем плохо, наступает время антибиотиков, таких как ЦИПРО широкого спектра действия.
Еще от Fox: Зубочистка Виновник таинственных проблем с печенью у женщины
После выздоровления от пищевого отравления примите хороший пробиотик.Вашему кишечнику требуется здоровая колония обильных полезных бактерий для переваривания пищи, удаления отходов, избавления кишечника от токсинов и снижения вероятности кишечного воспаления. Дружественные бактерии в пробиотиках помогают восстановить нормальную, здоровую функцию кишечника и пищеварения, помогая вам вернуться к нормальной жизни. Ищите йогурты или добавки с надписью «живые активные культуры» прямо на этикетке, чтобы гарантировать, что дружественные жуки все еще живы и жизнеспособны.
Pearls IC от Enzymatic Therapy — моя любимая из всех пробиотических добавок.
Кем бы вы ни были, вы можете получить пищевое отравление просто потому, что существует так много болезнетворных микроорганизмов, которые могут попасть в пищу. Следуйте инструкциям по безопасному обращению с пищевыми продуктами, и вы снизите риск. Но если вы заболели, хорошо быть готовым.
Этот контент создается и поддерживается третьей стороной и импортируется на эту страницу, чтобы помочь пользователям указать свои адреса электронной почты. Вы можете найти больше информации об этом и подобном контенте на фортепиано.ио
Причины и симптомы сальмонеллеза
Сальмонеллез представляет собой инфекцию, вызванную бактериями, называемыми Salmonella , Salmonella , обитающими в кишечных трактах животных, в том числе
птицы. Salmonella обычно передаются человеку через пищу
продукты, загрязненные фекалиями животных.
Ежегодно регистрируется около 40 000 случаев сальмонеллеза. В Соединенных Штатах.Поскольку многие более легкие случаи не диагностируются и не регистрируются, реальное число инфекций может быть в тридцать и более раз больше. Примерно Ежегодно в Миннесоте регистрируется от 700 до 925 случаев сальмонеллеза.
На этой странице:
Информационные бюллетени
Симптомы
Продолжительность болезни
Передача
Информационные бюллетени
Симптомы
Симптомы включают:
- диарея
- боли в животе и спазмы
- лихорадка
Симптомы обычно проявляются через 12–96 часов после заражения, но могут проявиться и через 2 недели после заражения.
Продолжительность болезни
- Инфекция Salmonella обычно проходит через 5-7 дней.

Трансмиссия
Загрязненные пищевые продукты часто имеют животное происхождение, такое как птица, свинина, говядина, птица, молоко или яйца, но все продукты, включая овощи, могут загрязняться.
Многие сырые продукты животного происхождения часто загрязняются, но, к счастью, тщательное приготовление убивает сальмонелл .
Пищевые продукты также могут быть заражены немытыми руками инфицированного работник пищевой промышленности, который не вымыл руки должным образом после употребления ванная комната.
Сальмонелла также может быть обнаружена в фекалиях некоторых домашних животных, и люди могут заражаются, если не моют руки после контакта с животными.
- Рептилии и цыплята/утята особенно часто
Сальмонелла.
- Люди всегда должны мыть руки сразу после контакта
эти животные.

- Взрослые также должны следить за тем, чтобы дети мыли руки после обращения с рептилией.
- Люди всегда должны мыть руки сразу после контакта
эти животные.
Подозреваете ли вы, что у вас болезнь пищевого или водного происхождения? Посещение с сообщением о подозрении на болезни пищевого/водного происхождения.
Что такое сальмонелла? Симптомы, причины, диагностика, лечение и профилактика
Ваше лечение сальмонеллы будет зависеть от таких факторов, как симптомы, возраст и общее состояние здоровья. Большинство случаев сальмонеллеза выздоравливают в течение недели без какого-либо лечения. По данным Национального института диабета, болезней органов пищеварения и почек (NIDDK), основной проблемой при пищевом отравлении — сальмонеллой или другими инфекционными организмами — является обезвоживание, вызванное рвотой и диареей.Ниже приведены некоторые советы, которые ваш врач может порекомендовать для лечения ваших симптомов в домашних условиях.
1. Пейте много жидкости, такой как:
- Вода
- Разбавленный фруктовый сок
- Спортивные напитки (которые могут восполнить потерянные электролиты)
- Прозрачные бульоны
- Педиалит или аналог электролита обратитесь к врачу, прежде чем принимать или давать их)
2. Если вам трудно что-либо удержать, попробуйте пить небольшое количество воды или сосать кусочки льда.
3. Ешьте соленые крекеры или крендели для восполнения электролитов (натрий является электролитом)
4. Ешьте небольшими порциями в течение дня.
5. Не принимайте противодиарейные препараты, если это не рекомендовано врачом; эти лекарства могут продлить диарею от сальмонеллезной инфекции. Если ваш врач обеспокоен тем, что вы можете подвергаться риску сильного обезвоживания, или если у вас высокая температура или сильная боль в животе, он или она может порекомендовать вам обратиться в больницу для лечения внутривенными жидкостями и наблюдения.
Если у вас ослаблена иммунная система или если ваши симптомы тяжелые и не улучшаются, ваш врач может назначить антибиотики для лечения сальмонеллезной инфекции. Согласно CDC, антибиотики могут быть рекомендованы для:
- Людей с тяжелым заболеванием (например, с высокой температурой, тяжелой диареей или бактериями, которые распространились в кровоток)
- Взрослым старше 50 лет с сопутствующими заболеваниями, такими как сердце Болезни
- Взрослые 65 лет и старше
- Младенцы младше 12 месяцев
- Люди с нарушенной или ослабленной иммунной системой (например, онкологические больные, проходящие химиотерапию, или люди с ВИЧ/СПИДом)
Врачи могут назначать антибиотики, такие как ципрофлоксацин , азитромицин и цефтриаксон для лечения пациентов с тяжелыми инфекциями сальмонеллы.Но тревожно то, что в последние годы устойчивые к антибиотикам сальмонеллы стали проблемой. Инфекции, вызванные этими «множественно-резистентными штаммами» сальмонеллы, могут быть более тяжелыми и приводить к более высоким показателям госпитализации.
Исследователи все еще изучают, как пробиотики могут помочь в лечении пищевых отравлений, таких как инфекции сальмонеллы, поэтому обязательно проконсультируйтесь со своим врачом, прежде чем использовать пробиотики или любые другие средства для лечения желудочно-кишечных заболеваний.
Но, учитывая растущую проблему устойчивых к антибиотикам штаммов сальмонеллы, потенциальные альтернативные методы лечения, такие как пробиотики, сегодня становятся все более важными.
Большинство инфекций, вызываемых сальмонеллезом, вызываются зараженными пищевыми продуктами. Лучший способ снизить риск заражения сальмонеллезом — соблюдать меры безопасности пищевых продуктов и принимать меры для предотвращения пищевых отравлений.
Соблюдайте четыре правила безопасности пищевых продуктов, рекомендованные CDC:- Чистота Часто мойте руки и поверхности, такие как разделочные доски и столешницы, а также промывайте фрукты и овощи под проточной водой.
- Отдельно Избегайте перекрестного загрязнения, используя отдельную разделочную доску для сырого мяса, птицы и морепродуктов и храня эти продукты отдельно от других продуктов
- Готовьте Убедитесь, что пища приготовлена до рекомендуемой внутренней температуры, чтобы убить микробы
- Охлаждение Поддерживайте температуру в холодильнике на уровне 40 градусов по Фаренгейту или ниже и никогда не оставляйте скоропортящиеся продукты вне холодильника более чем на два часа.
Размораживайте замороженные продукты в холодильнике или в микроволновой печи, потому что если оставить продукты на столе для разморозки, бактерии быстро размножатся.
Не забывайте также всегда тщательно мыть руки после посещения туалета или смены подгузников, а также мыть руки после контакта с животными.
Сальмонеллез
Рассмотрено: сентябрь 2017 г.
Что такое сальмонеллез?
Сальмонеллез — это инфекция, вызванная бактериями, называемыми Salmonella , которая обычно поражает кишечник (кишечник/кишечник) и иногда кровоток. Это одна из наиболее распространенных причин диарейных заболеваний: ежегодно в штате Нью-Йорк регистрируется несколько тысяч случаев.Большинство случаев приходится на летние месяцы и могут рассматриваться как единичные случаи или вспышки (когда два или более человека заболевают от одного и того же источника).
Кто болеет сальмонеллезом?
Заболеть сальмонеллезом может любой человек, но чаще его диагностируют у младенцев и детей.
Маленькие дети, пожилые люди и люди с ослабленной иммунной системой (например, люди с раком, ВИЧ/СПИДом или трансплантатом) наиболее подвержены тяжелым инфекциям.
Как распространяется сальмонеллез?
Инфекция распространяется при употреблении в пищу или питье зараженной пищи или воды или при контакте с людьми или животными, зараженными Salmonella . Salmonella можно найти в сыром или недоваренном мясе и яйцах, сыром (непастеризованном) молоке и сырных продуктах, а также в продуктах. Пищевые продукты также могут быть заражены бактериями Salmonella во время приготовления или обработки. Контакт с инфицированными животными, особенно с домашней птицей (курами, индейками, утками), свиньями (свиньями или свиньями), крупным рогатым скотом (коровами), грызунами (мышами или крысами) и домашними животными, такими как рептилии (игуаны, змеи, ящерицы и черепахи) , цыплята, утята, птицы, собаки и кошки могут распространять инфекцию.Предыдущие вспышки Salmonella в штате Нью-Йорк были связаны с арахисовым маслом, замороженными горшками, яйцами, кормами для домашних животных и черепахами.
Каковы симптомы сальмонеллеза и когда они появляются?
У больных сальмонеллезом может наблюдаться легкая или тяжелая диарея (жидкий стул/фекалии), спазмы желудка, лихорадка и иногда рвота. Инфекции кровотока могут возникать и быть довольно серьезными, особенно у очень молодых или пожилых людей. Некоторые инфицированные не испытывают никаких симптомов вообще.Симптомы обычно появляются от нескольких часов до трех дней после контакта с бактериями Salmonella .
Как диагностируется сальмонеллез?
Сальмонеллез диагностируется при обнаружении бактерий Salmonella в образце стула.
Чем лечить сальмонеллез?
Сальмонеллез обычно проходит через пять-семь дней и часто не требует лечения, если только у инфицированного человека не возникает сильное обезвоживание (потеря жидкости в организме, вызывающая слабость или головокружение) или инфекция не распространяется из кишечника на другие части тела.Людям с тяжелой диареей (жидкий стул/фекалии) может потребоваться регидратация, часто с внутривенным введением жидкостей.
Антибиотики обычно не нужны, если инфекция не распространяется из кишечника.
Дает ли перенесенная инфекция сальмонеллеза иммунитет?
Люди могут повторно заразиться сальмонеллезом при повторном контакте с бактериями.
Нужно ли изолировать инфицированных людей или исключать их из работы или учебы?
Большинство инфицированных людей могут вернуться на работу или в школу, когда их диарея (жидкий стул/кал) прекратилась.Работники общественного питания, медицинский персонал и дети в детских садах должны получить разрешение местного или государственного департамента здравоохранения, прежде чем вернуться к своей обычной деятельности. Инфицированный человек может нести бактерии в течение нескольких дней или нескольких месяцев. Люди, которые лечились пероральными антибиотиками, и молодые люди, как правило, являются переносчиками бактерий дольше, чем другие.
Как предотвратить сальмонеллез?
- Всегда обращайтесь с сырой птицей, говядиной и свининой соответственно:
- Заверните свежее мясо в полиэтиленовые пакеты на рынке, чтобы кровь и соки не попали на другие продукты.
Быстро охлаждайте продукты; и не храните пищу при комнатной температуре. - Никогда не кладите приготовленную пищу на немытую поверхность, на которой ранее находилась сырая говядина, птица, свинина, рыба или морепродукты.
- Разделочные доски и столы, используемые для приготовления говядины, птицы, свинины, рыбы или морепродуктов, следует мыть сразу после использования, чтобы предотвратить перекрестное загрязнение с другими продуктами.
- Избегайте употребления сырого или недоваренного мяса. Хотя цвет сока обычно меняется с красного на серый, когда мясо полностью приготовлено, это не надежный тест, чтобы гарантировать, что его можно есть.
- Всегда проверяйте температуру мясным термометром. Продукты, достигшие температуры, указанной ниже или выше, считаются полностью приготовленными.
Продукты питания Температура Цыпленок 165°F Гамбургер 160°F Свинина 150°F Хот-доги 140°F Остатки 165°F Яйца 145°F Другие продукты 140°F - Чтобы проверить температуру мяса, вставьте термометр в самую толстую часть мяса, которая является наименее приготовленной.
Для проверки хот-догов идите от конца хот-дога к центру. Будьте осторожны, чтобы не проткнуть мясо и не коснуться варочной поверхности, иначе вы получите ложные показания высокой температуры. - Дополнительные советы по приготовлению пищи и профилактике заболеваний можно найти в разделе «Советы по безопасности пищевых продуктов для барбекю» .
- Заверните свежее мясо в полиэтиленовые пакеты на рынке, чтобы кровь и соки не попали на другие продукты.
- Избегайте употребления в пищу сырых яиц или недоваренных продуктов, содержащих сырые яйца. Сырые яйца могут быть не распознаны в некоторых продуктах, таких как домашний голландский соус, цезарь и другие домашние заправки для салатов, тирамису, домашнее мороженое, домашний майонез, домашний гоголь-моголь, тесто для печенья и глазурь.
- Избегайте употребления сырого (непастеризованного) молока.
- Мойте фрукты и овощи под проточной водой перед едой.
- Поощряйте тщательное мытье рук водой с мылом до и после приготовления пищи.
- Мойте руки (особенно детям) водой с мылом сразу после контакта с рептилиями, контакта с фекалиями домашних животных (фекалиями) или работы с кормом или лакомствами для домашних животных.





Это гарантирует не только Вашу безопасность, но и вкусовые качества блюда.







Этого легче добиться, «взбивая» яйца, а не готовя их «солнечной стороной вверх» или «слишком легко».«Удостоверьтесь, что все продукты, содержащие яйца, приготовлены до 160 градусов.
Пищу следует хранить в холодильнике при температуре 40°F или ниже.
морозильная камера с температурой 0°F или ниже. 
**
д. горячей мыльной водой перед тем, как прикасаться к пище. 

Размораживайте замороженные продукты в холодильнике или в микроволновой печи, потому что если оставить продукты на столе для разморозки, бактерии быстро размножатся.
Быстро охлаждайте продукты; и не храните пищу при комнатной температуре.
Для проверки хот-догов идите от конца хот-дога к центру. Будьте осторожны, чтобы не проткнуть мясо и не коснуться варочной поверхности, иначе вы получите ложные показания высокой температуры.